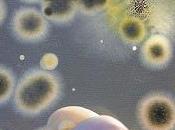
experto dice España tiene vigilar E-coli otros países

Ferrecons
compartido
MIS BLOGS
-
Ferré & Consulting Blog
http://blog.ferreconsulting.com/
Noticias, artículos y novedades sobre las artes blancas
ÚLTIMOS ARTÍCULOS (618)
-
Alfa Laval revoluciona el control de válvulas mariposa

El actuador del Unique Control LKB es el más duradero que existe. Su inteligente diseño integrado cuenta con una carcasa que le hace resistente a los entornos... Leer el resto
Publicado el 11 mayo 2012 EMPRESA -
La intolerancia alimentaria de sus hijos lleva a una pareja a crear empresa

La intolerancia de sus hijos hizo que una pareja de Vandellòs se lanzara a la fabricación y comercialización de bollería sin leche ni huevo, una iniciativa que... Leer el resto
Publicado el 11 mayo 2012 EMPRESA -
Barcelona Tecnologías de la Alimentación celebra su XIII edición del 15 al 18...

Barcelona Tecnologías de la Alimentación- celebra su decimotercera edición centrada en la internacionalización y la innovación. Leer el resto
Publicado el 11 mayo 2012 EMPRESA -
Un experto dice que España tiene que vigilar la E-coli más que otros países
El director del Laboratorio de Referencia de "E. coli" de la Facultad de Veterinaria de Lugo, Jorge Blanco, reconoció que España tiene que "hacer más controles... Leer el resto
Publicado el 11 mayo 2012 EMPRESA -
La turronera Almendra y Miel acusa a la banca de impedirle la compra de Doña...

En el procedimiento concursal de Productos J. Jiménez, el auto del juez ha pospuesto la venta de los activos de la empresa ante la oposición de los bancos a... Leer el resto
Publicado el 11 mayo 2012 EMPRESA -
El Eurocámara no aprueba las cuentas de la EFSA por el elevado coste de sus...

La Eurocámara aprobó ayer la gestión presupuestaria de todas las agencias europeas, salvo la agencia de medicamentos, con sede en Londres; la agencia de... Leer el resto
Publicado el 11 mayo 2012 ECONOMÍA, EMPRESA -
Bellsolà fabrica 18,000 baguettes la hora

Las barras de pan de la empresa Bellsolà las podemos encontrar en gasolineras, supermercados como Caprabo y cadenas de hoteles como Iberostar. Leer el resto
Publicado el 11 mayo 2012 EMPRESA -
El nuevo pan de siempre

A veces, curiosamente, la novedad está en la recuperación de nuestras mejores tradiciones. Es lo que sucede con el pan, que últimamente ha experimentado todo... Leer el resto
Publicado el 11 mayo 2012 COCINA -
Danone invierte 9 millones en entrar en el negocio del helado

La filial española de Danone se ha convertido en la gran factoría de ideas de la multinacional gala. La compañía presidida por Javier Robles lanzará en mayo... Leer el resto
Publicado el 11 mayo 2012 COMUNICACIÓN, EMPRESA, INSÓLITO -
Nestlé compra Pfizer Nutrition por 11.850 mdd

La compañía Nestlé ha estimado que el volumen de negocios, al finalizar el año 2012, de Pfizer Nutrition, será de 2.400 millones de dólares. El gigante suizo d... Leer el resto
Publicado el 04 mayo 2012 EMPRESA -
Pan barra de cristal

Les adjuntamos algunas imagenes de un reciente desarrollo de pan barra de cristal en el laboratorio y planta piloto de Ferré & Consulting Group... Leer el resto
Publicado el 04 mayo 2012 EMPRESA -
Sensores inalámbricos, pieza esencial en la cadena del frío de los alimentos

Un Proyecto Fin de Carrera realizado en la Universidad Politécnica de Madrid (UPM) da un paso más para conseguir una cadena del frío realmente eficiente, con... Leer el resto
Publicado el 04 mayo 2012 EMPRESA -
Consumidores y sector agroalimentario valoran positivamente el reconocimiento...

El Ministerio de Agricultura, Alimentación y Medio Ambiente, a través del Barómetro del Clima de Confianza del sector Agroalimentario, ha llevado a cabo un... Leer el resto
Publicado el 04 mayo 2012 EMPRESA -
Casa Tarradellas construye una planta de reciclaje y co-extrusión de plástico PET
Casa Tarradellas está construyendo una fábrica para recuperar y reutilizar los recortes de material PET, que actualmente se producen en sus líneas de envasado,... Leer el resto
Publicado el 04 mayo 2012 EMPRESA -
Alimentación y bebidas, exportaciones récord

Las exportaciones de la industria española de alimentación y bebidas representan casi un cuarto del sector (24%) y en el último año han crecido un 12%, el... Leer el resto
Publicado el 04 mayo 2012 EMPRESA -
Panrico presenta un ERE que afecta a 121 trabajadores en toda España

Es el resultado de varios acuerdos a los que Panrico ha llegado con los sindicatosPanrico ha presentado ante el Ministerio de Empleo un Expediente de... Leer el resto
Publicado el 04 mayo 2012 EMPRESA -
Galletas Gullón obtuvo durante 2011 un beneficio neto de 14,9 millones de euros

Galletas Gullón obtuvo durante 2011 un beneficio neto de 14,9 millones de euros, un 29 por ciento menos que el pasado año debido a la subida del precio de las... Leer el resto
Publicado el 04 mayo 2012 EMPRESA -
¿Manipular el aroma de los alimentos puede ayudar a regular el consumo de...

Según la investigación de científicos de la Universidad de Wageningen, el Top Institute Food and Nutrition, y NIZO Food Research, publicada en Flavour, el tamañ... Leer el resto
Publicado el 04 mayo 2012 EMPRESA -
Convocado en Cataluña el Premio a la Innovación Tecnológica Agroalimentaria 2012

Convocado en Cataluña el Premio a la Innovación Tecnológica Agroalimentaria 2012 con una nueva modalidad para el joven emprendedor innovador Leer el resto
Publicado el 28 abril 2012 EMPRESA -
Solé Graells comprado por Guzmán Gastronomía

Guzmán Gastronomía crece mediante adquisiciones. La compañía catalana de servicios de restauración ampliará su oferta con la compra de Solé Graells, una... Leer el resto
Publicado el 28 abril 2012 EMPRESA
